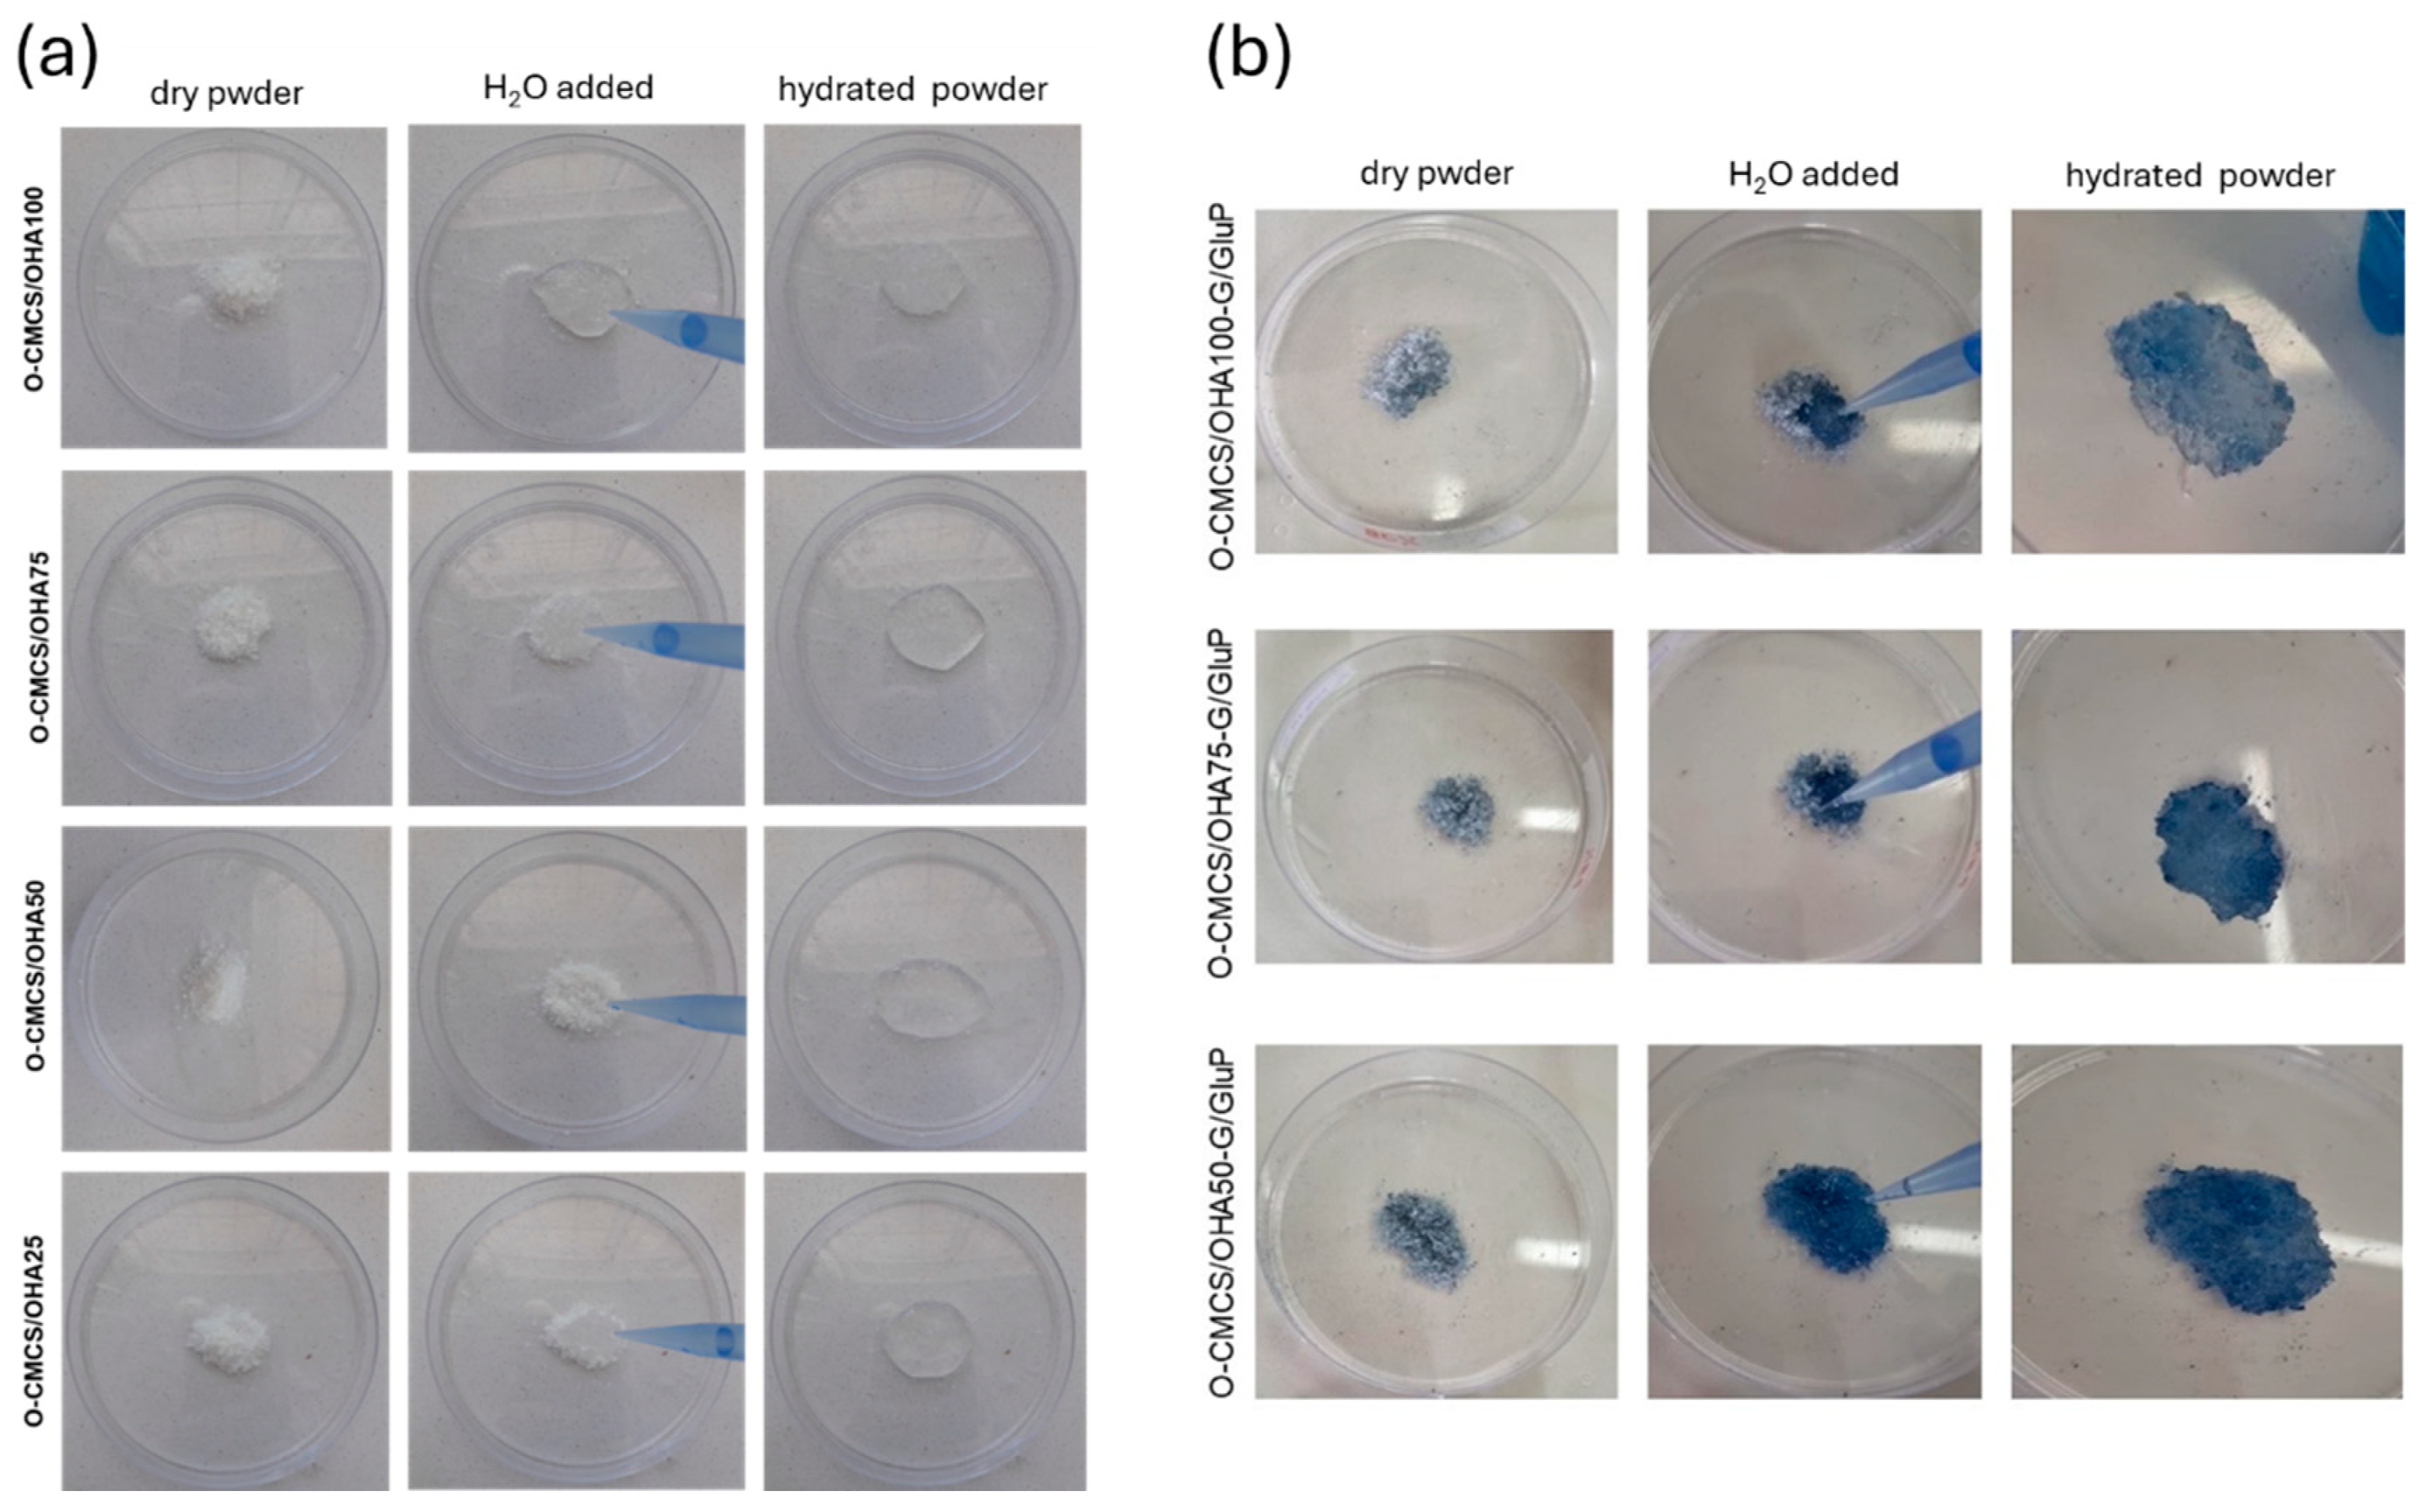
Polymers 16 02615 g004 Polymers 16 02615 g004

Rheological Characterization of Genipin-Based Crosslinking Pigment and O-Carboxymethyl Chitosan–Oxidized Hyaluronic Acid In Situ Formulable Hydrogels
Abstract
1. Introduction
2. Experimental Methods
2.1. Materials
2.2. Synthesis of O-Carboxymethyl Chitosan (O-CMCS)
2.3. Synthesis of Oxidized Hyaluronic Acid (OHA)
2.4. Synthesis of the Genipin–Glutamic Acid Crosslinker Pigment (G/GluP)
2.5. Synthesis of O-CMCS/OHA Powder without and with the Crosslinker Pigment and Characterization of O-CMCS/OHA Hydrogels
2.6. Characterization
3. Results and Discussion
3.1. Organoleptic Properties and FTIR of Hydrogel Precursors
3.1.1. O-Carboxymethyl Chitosan (O-CMCS)
3.1.2. Oxidized Hyaluronic Acid (OHA)
3.1.3. Crosslinker Pigment (G/GluP)
3.1.4. O-CMCS/OHA and O-CMCS/OHA-G/GluP Powders
3.2. Rheological Properties of Hydrogels
4. Conclusions
Author Contributions
Funding
Data Availability Statement
Acknowledgments
Conflicts of Interest
References
- Navarro, R.F. Modelos Viscoelásticos Aplicáveis a Materiais Reais: Uma revisão. Rev. Eletrônica De Mater. E Process. REMAP 2007, 12, 1–20. [Google Scholar]
- Craciun, A.M.; Morariu, S.; Marin, L. Self-healing chitosan hydrogels: Preparation and rheological characterization. Polymers 2022, 14, 2570. [Google Scholar] [CrossRef] [PubMed]
- Liu, Y.; Hsu, S.-h. Synthesis and biomedical applications of self-healing hydrogels. Front. Chem. 2018, 6, 449. [Google Scholar] [CrossRef] [PubMed]
- Wang, Q.; Zhang, Y.; Ma, Y.; Wang, M.; Pan, G. Nano-crosslinked dynamic hydrogels for biomedical applications. Mater. Today Bio. 2023, 20, 100640. [Google Scholar] [CrossRef] [PubMed]
- Yin, B.; Gosecka, M.; Bodaghi, M.; Crespy, D.; Youssef, G.; Dodda, J.M.; Wong, S.H.D.; Imran, A.B.; Gosecki, M.; Jobdeedamrong, A.; et al. Engineering multifunctional dynamic hydrogel for biomedical and tissue regenerative applications. Chem. Eng. J. 2024, 487, 150403. [Google Scholar] [CrossRef]
- Klopp, L.S.; Toth, J.M.; Welch, W.C.; Rao, S.; Tai, J.W.; Thomas, K.A.; Turner, S. Bioresorbable film for the prevention of adhesion to the anterior spine after anterolateral discectomy. Spine J. 2009, 9, 411–417. [Google Scholar] [CrossRef][Green Version]
- Klopp, L.S.; Simon, B.J.; Bush, J.M.; Enns, R.M.; Turner, A.S. Comparison of a caprolactone/lactide film (mesofol) to two polylactide film products as a barrier to postoperative peridural adhesion in an ovine dorsal laminectomy model. Spine 2008, 33, 1518–1526. [Google Scholar] [CrossRef]
- Li, J.; Feng, X.; Liu, B.; Yu, Y.; Sun, L.; Liu, T.; Wang, Y.; Ding, J.; Chen, X. Polymer materials for prevention of postoperative adhesion. Acta Biomater. 2017, 61, 21–40. [Google Scholar] [CrossRef]
- Jia, Y.; Feng, J.; Feng, Z.; Liu, J.; Yang, Y.; Li, X.; Lei, M.; Guo, H.; Wei, Z.; Lv, Y. An endoscopically compatible fast-gelation powder forms Janus-adhesive hydrogel barrier to prevent postoperative adhesions. Proc. Natl. Acad. Sci. USA 2023, 120, e2219024120. [Google Scholar] [CrossRef]
- Stapleton, L.M.; Steele, A.N.; Wang, H.; Lopez Hernandez, H.; Yu, A.C.; Paulsen, M.J.; Smith, A.A.A.; Roth, G.A.; Thakore, A.D.; Lucian, H.J. Use of a supramolecular polymeric hydrogel as an effective post-operative pericardial adhesion barrier. Nat. Biomed. Eng. 2019, 3, 611–620. [Google Scholar] [CrossRef]
- Aksakal, N.; Goksoy, B.; Onder, S.Y.; Dogan, S.; Gok, A.F.K.; Barbaros, U. A new cross-linked hyaluronic acid gel for preventing adhesion after thyroid surgery: An animal study. J. Surg. Res. 2021, 265, 147–152. [Google Scholar] [CrossRef] [PubMed]
- Pan, X.; Ren, C.; Hu, B.; Li, F.; Li, G.; Zhou, H.; Jin, L. Nanofibers and hydrogel composite patch with sandwich structure for prevention post-operative abdominal adhesion. Mater. Des. 2024, 239, 112775. [Google Scholar] [CrossRef]
- Diamond, M.P. Reduction of postoperative adhesion development. Fertil. Steril. 2016, 106, 994–997. [Google Scholar] [CrossRef] [PubMed]
- Moris, D.; Chakedis, J.; Rahnemai-Azar, A.A.; Wilson, A.; Hennessy, M.M.; Athanasiou, A.; Beal, E.W.; Argyrou, C.; Felekouras, E.; Pawlik, T.M. Postoperative abdominal adhesions: Clinical significance and advances in prevention and management. J. Gastrointest. Surg. 2017, 21, 1713–1722. [Google Scholar] [CrossRef]
- Jiamsripong, P.; Alharthi, M.S.; Calleja, A.M.; McMahon, E.M.; Katayama, M.; Westerdale, J.; Milano, M.; Heys, J.J.; Mookadam, F.; Belohlavek, M. Impact of pericardial adhesions on diastolic function as assessed by vortex formation time, a parameter of transmitral flow efficiency. Cardiovasc. Ultrasound 2010, 8, 42. [Google Scholar] [CrossRef]
- Ten Broek, R.P.G.; Issa, Y.; van Santbrink, E.J.P.; Bouvy, N.D.; Kruitwagen, R.F.P.M.; Jeekel, J.; Bakkum, E.A.; Rovers, M.M.; van Goor, H. Burden of adhesions in abdominal and pelvic surgery: Systematic review and met-analysis. Bmj 2013, 347, f5588. [Google Scholar] [CrossRef]
- Silva, I.C.M.; Netto, I.d.P.; Vartanian, J.G.; Kowalski, L.P.; Angelis, E.C.-d. Prevalence of upper aerodigestive symptoms in patients who underwent thyroidectomy with and without the use of intraoperative laryngeal nerve monitoring. Thyroid 2012, 22, 814–819. [Google Scholar] [CrossRef]
- Van Goor, H. Consequences and complications of peritoneal adhesions. Color. Dis. 2007, 9, 25–34. [Google Scholar] [CrossRef]
- Baakdah, H.; Tulandi, T. Adhesion in gynecology complication, cost, and prevention: A review. Surg. Technol. Int. 2005, 14, 185–190. [Google Scholar]
- Rajab, T.K.; Wallwiener, M.; Planck, C.; Brochhausen, C.; Kraemer, B.; Wallwiener, C.W. A direct comparison of seprafilm, adept, intercoat, and spraygel for adhesion prophylaxis. J. Surg. Res. 2010, 161, 246–249. [Google Scholar] [CrossRef]
- Fossum, G.T.; Silverberg, K.M.; Miller, C.E.; Diamond, M.P.; Holmdahl, L. Gynecologic use of Sepraspray Adhesion Barrier for reduction of adhesion development after laparoscopic myomectomy: A pilot study. Fertil. Steril. 2011, 96, 487–491. [Google Scholar] [CrossRef] [PubMed]
- Gong, P.; Ren, L.; Gao, X.; Long, J.; Tian, W.; He, M. A novel barrier membrane with long-term ROS scavenging function for complete prevention of postoperative adhesion. Mater. Des. 2024, 238, 112691. [Google Scholar] [CrossRef]
- Qu, X.; Sang, X.; Lv, Y.; Wang, C.; Hu, P.; Guo, Q.; Liu, Y. PLLA-COI multilayer nanofiber membrane for anti-adhesion of the Achilles tendon. Mater. Today Commun. 2024, 38, 107595. [Google Scholar] [CrossRef]
- Holme, H.K.; Davidsen, L.; Kristiansen, A.; Smidsrød, O. Kinetics and mechanisms of depolymerization of alginate and chitosan in aqueous solution. Carbohydr. Polym. 2008, 73, 656–664. [Google Scholar] [CrossRef] [PubMed]
- Beck, E.C.; Lohman, B.L.; Tabakh, D.B.; Kieweg, S.L.; Gehrke, S.H.; Berkland, C.J.; Detamore, M.S. Enabling surgical placement of hydrogels through achieving paste-like rheological behavior in hydrogel precursor solutions. Ann. Biomed. Eng. 2015, 43, 2569–2576. [Google Scholar] [CrossRef]
- Chen, C.-H.; Chen, S.-H.; Mao, S.-H.; Tsai, M.-J.; Chou, P.-Y.; Liao, C.-H.; Chen, J.-P. Injectable thermosensitive hydrogel containing hyaluronic acid and chitosan as a barrier for prevention of postoperative peritoneal adhesion. Carbohydr. Polym. 2017, 173, 721–731. [Google Scholar] [CrossRef]
- Akhlaghi, S.; Ebrahimnia, M.; Niaki, D.S.; Solhi, M.; Rabbani, S.; Haeri, A. Recent advances in the preventative strategies for postoperative adhesions using biomaterial-based membranes and micro/nano-drug delivery systems. J. Drug Deliv. Sci. Technol. 2023, 85, 104539. [Google Scholar] [CrossRef]
- Park, H.; Baek, S.; Kang, H.; Lee, D. Biomaterials to prevent post-operative adhesion. Materials 2020, 13, 3056. [Google Scholar] [CrossRef]
- Vakilian, S.; Al-Hashmi, S.; Al-kindi, J.; Al-Fahdi, F.; Al-Wahaibi, N.; Shalaby, A.; Al-Riyami, H.; Al-Harrasi, A.; Jamshidi-adegani, F. Avastin-Loaded 3D-Printed Alginate Scaffold as an Effective Antiadhesive Barrier to Prevent Postsurgical Adhesion Bands Formation. Macromol. Biosci. 2024, 24, 2300530. [Google Scholar] [CrossRef]
- Zhang, W.; He, Y.; Chu, Y.; Zhai, Y.; Qian, S.; Wang, X.; Jiang, P.; Cui, P.; Zhang, Y.; Wang, J. Amorphous curcumin-based hydrogels to reduce the incidence of post-surgical intrauterine adhesions. Regen. Biomater. 2024, 11, rbae043. [Google Scholar] [CrossRef]
- Blacklow, S.O.; Li, J.; Freedman, B.R.; Zeidi, M.; Chen, C.; Mooney, D.J. Bioinspired mechanically active adhesive dressings to accelerate wound closure. Sci. Adv. 2019, 5, eaaw3963. [Google Scholar] [CrossRef] [PubMed]
- Li, J.; Celiz, A.D.; Yang, J.; Yang, Q.; Wamala, I.; Whyte, W.; Seo, B.R.; Vasilyev, N.V.; Vlassak, J.J.; Suo, Z. Tough adhesives for diverse wet surfaces. Science 2017, 357, 378–381. [Google Scholar] [CrossRef] [PubMed]
- Cortes, H.; Caballero-Florán, I.H.; Mendoza-Muñoz, N.; Córdova-Villanueva, E.N.; Escutia-Guadarrama, L.; Figueroa-González, G.; Reyes-Hernández, O.D.; González-Del Carmen, M.; Varela-Cardoso, M.; Magaña, J.J. Hyaluronic acid in wound dressings. Cell. Mol. Biol. 2020, 66, 191–198. [Google Scholar] [CrossRef] [PubMed]
- De Clercq, K.; Schelfhout, C.; Bracke, M.; De Wever, O.; Van Bockstal, M.; Ceelen, W.; Remon, J.P.; Vervaet, C. Genipin-crosslinked gelatin microspheres as a strategy to prevent postsurgical peritoneal adhesions: In vitro and in vivo characterization. Biomaterials 2016, 96, 33–46. [Google Scholar] [CrossRef]
- Zheng, J.; Li, K.; Li, Y.; Jiang, G. Preparation and characterization of carboxymethyl chitosan/κ-carrageenan/silver nanoparticles sponge for wound dressing. Mater. Today Commun. 2023, 35, 105818. [Google Scholar] [CrossRef]
- Chen, L.; Xie, Y.; Chen, X.; Li, H.; Lu, Y.; Yu, H.; Zheng, D. O-carboxymethyl chitosan in biomedicine: A review. Int. J. Biol. Macromol. 2024, 275, 133465. [Google Scholar] [CrossRef]
- Malkin, A.Y.; Derkach, S.R. Gelation of polymer solutions as a rheological phenomenon (mechanisms and kinetics). Curr. Opin. Colloid Interface Sci. 2024, 73, 101844. [Google Scholar] [CrossRef]
- Payet, L.; Ponton, A.; Grossiord, J.L.; Agnely, F. Structural and rheological properties of chitosan semi-interpenetrated networks. Eur. Phys. J. E 2010, 32, 109–118. [Google Scholar] [CrossRef]
- Diez-Sales, O.; Dolz, M.; Hernandez, M.J.; Casanovas, A.; Herraez, M. Rheological characterization of chitosan matrices: Influence of biopolymer concentration. J. Appl. Polym. Sci. 2007, 105, 2121–2128. [Google Scholar] [CrossRef]
- Derkach, S.R.; Voron’ko, N.G.; Sokolan, N.I. The rheology of hydrogels based on chitosan–gelatin (bio) polyelectrolyte complexes. J. Dispers. Sci. Technol. 2017, 38, 1427–1434. [Google Scholar] [CrossRef]
- Wang, Y.; Qiu, D.; Cosgrove, T.; Denbow, M.L. A small-angle neutron scattering and rheology study of the composite of chitosan and gelatin. Colloids Surf. B Biointerfaces 2009, 70, 254–258. [Google Scholar] [CrossRef] [PubMed]
- Nilsen-Nygaard, J.; Strand, S.P.; Vårum, K.M.; Draget, K.I.; Nordgård, C.T. Chitosan: Gels and interfacial properties. Polymers 2015, 7, 552–579. [Google Scholar] [CrossRef]
- Seetapan, N.; Mai-ngam, K.; Plucktaveesak, N.; Sirivat, A. Linear viscoelasticity of thermoassociative chitosan-g-poly (N-isopropylacrylamide) copolymer. Rheol. Acta 2006, 45, 1011–1018. [Google Scholar] [CrossRef]
- Mikešová, J.; Hašek, J.; Tishchenko, G.; Morganti, P. Rheological study of chitosan acetate solutions containing chitin nanofibrils. Carbohydr. Polym. 2014, 112, 753–757. [Google Scholar] [CrossRef] [PubMed]
- Montembault, A.; Viton, C.; Domard, A. Rheometric study of the gelation of chitosan in a hydroalcoholic medium. Biomaterials 2005, 26, 1633–1643. [Google Scholar] [CrossRef]
- Cho, J.; Heuzey, M.-C.; Bégin, A.; Carreau, P.J. Chitosan and glycerophosphate concentration dependence of solution behaviour and gel point using small amplitude oscillatory rheometry. Food Hydrocoll. 2006, 20, 936–945. [Google Scholar] [CrossRef]
- Alam, K.; Iqbal, M.; Hasan, A.; Al-Maskari, N. Rheological characterization of biological hydrogels in aqueous state. J. Appl. Biotechnol. Rep. 2020, 7, 171–175. [Google Scholar]
- Friedrich, C.H.R.; Heymann, L. Extension of a model for crosslinking polymer at the gel point. J. Rheol. 1988, 32, 235–241. [Google Scholar] [CrossRef]
- Friedrich, C.; Heymann, L.; Berger, H.R. Evolution of time constants during sol-gel transition. Rheol. Acta 1989, 28, 535–539. [Google Scholar] [CrossRef]
- Galdino, T.P.; de Oliveira, L.C.; Lima, E.P.N.; Farias, R.Í.R.; de Jesus, R.A.; de Queiroz, S.F.A.M.; de Queiroz Santos, A.C.; Fook, M.V.L. Síntese e caracterização da O-Carboximetilquitosana como alternativa ao uso do Ácido Hialurônico. Res. Soc. Dev. 2022, 11, e5011527634. [Google Scholar] [CrossRef]
- Jha, A.K.; Hule, R.A.; Jiao, T.; Teller, S.S.; Clifton, R.J.; Duncan, R.L.; Pochan, D.J.; Jia, X. Structural Analysis and Mechanical Characterization of Hyaluronic Acid-Based Doubly Cross-Linked Networks. Macromolecules 2009, 42, 537–546. [Google Scholar] [CrossRef] [PubMed]
- Jia, X.; Colombo, G.; Padera, R.; Langer, R.; Kohane, D.S. Prolongation of sciatic nerve blockade by in situ cross-linked hyaluronic acid. Biomaterials 2004, 25, 4797–4804. [Google Scholar] [CrossRef] [PubMed]
- Nair, S.; Remya, N.S.; Remya, S.; Nair, P.D. A biodegradable in situ injectable hydrogel based on chitosan and oxidized hyaluronic acid for tissue engineering applications. Carbohydr. Polym. 2011, 85, 838–844. [Google Scholar] [CrossRef]
- Tan, H.; Rubin, J.P.; Marra, K.G. Injectable in situ forming biodegradable chitosan-hyaluronic acid based hydrogels for adipose tissue regeneration. Organogenesis 2010, 6, 173–180. [Google Scholar] [CrossRef] [PubMed]
- Kristiansen, K.A.; Potthast, A.; Christensen, B.E. Periodate oxidation of polysaccharides for modification of chemical and physical properties. Carbohydr. Res. 2010, 345, 1264–1271. [Google Scholar] [CrossRef]
- Paik, Y.-S.; Lee, C.-M.; Cho, M.-H.; Hahn, T.-R. Physical stability of the blue pigments formed from geniposide of gardenia fruits: Effects of pH, temperature, and light. J. Agric. Food Chem. 2001, 49, 430–432. [Google Scholar] [CrossRef]
- Cho, Y.J.; Kim, S.Y.; Kim, J.; Choe, E.K.; Kim, S.I.; Shin, H.J. One-step enzymatic synthesis of blue pigments from geniposide for fabric dyeing. Biotechnol. Bioprocess Eng. 2006, 11, 230–234. [Google Scholar] [CrossRef]
- Ahmed, R.; ul ain Hira, N.; Wang, M.; Iqbal, S.; Yi, J.; Hemar, Y. Genipin, a natural blue colorant precursor: Source, extraction, properties, and applications. Food Chem. 2023, 434, 137498. [Google Scholar] [CrossRef]
- Bai, R.; Yong, H.; Zhang, X.; Liu, J.; Liu, J. Structural characterization and protective effect of gallic acid grafted O-carboxymethyl chitosan against hydrogen peroxide-induced oxidative damage. Int. J. Biol. Macromol. 2020, 143, 49–59. [Google Scholar] [CrossRef]
- Wang, L.; Guo, R.; Liang, X.; Ji, Y.; Zhang, J.; Gai, G.; Guo, Z. Preparation and Antioxidant Activity of New Carboxymethyl Chitosan Derivatives Bearing Quinoline Groups. Mar. Drugs 2023, 21, 606. [Google Scholar] [CrossRef]
- Anitha, A.; Rani, V.V.D.; Krishna, R.; Sreeja, V.; Selvamurugan, N.; Nair, S.V.; Tamura, H.; Jayakumar, R. Synthesis, characterization, cytotoxicity and antibacterial studies of chitosan, O-carboxymethyl and N, O-carboxymethyl chitosan nanoparticles. Carbohydr. Polym. 2009, 78, 672–677. [Google Scholar] [CrossRef]
- Maiz-Fernández, S.; Pérez-Álvarez, L.; Silván, U.; Vilas-Vilela, J.L.; Lanceros-Méndez, S. Dynamic and self-healable chitosan/hyaluronic acid-based in situ-forming hydrogels. Gels 2022, 8, 477. [Google Scholar] [CrossRef] [PubMed]
- Wójcik-Pastuszka, D.; Skrzypczyk, A.; Musiał, W. The interactions and release kinetics of sodium hyaluronate implemented in nonionic and anionic polymeric hydrogels, studied by immunoenzymatic ELISA test. Pharmaceutics 2021, 14, 58. [Google Scholar] [CrossRef] [PubMed]
- Li, L.; Wang, N.; Jin, X.; Deng, R.; Nie, S.; Sun, L.; Wu, Q.; Wei, Y.; Gong, C. Biodegradable and injectable in situ cross-linking chitosan-hyaluronic acid based hydrogels for postoperative adhesion prevention. Biomaterials 2014, 35, 3903–3917. [Google Scholar] [CrossRef] [PubMed]
- Nguyen, N.T.-P.; Nguyen, L.V.-H.; Tran, N.M.-P.; Nguyen, T.-H.; Huynh, C.-K.; Vo Van, T. Synthesis of Cross-Linking Chitosan-hyaluronic Acid Based Hydrogels for Tissue Engineering Applications; Springer: Berlin/Heidelberg, Germany, 2018; pp. 671–675. [Google Scholar]
- Li, S.; Hu, L.; Li, D.; Wang, X.; Zhang, P.; Wang, J.; Yan, G.; Tang, R. Carboxymethyl chitosan-based nanogels via acid-labile ortho ester linkages mediated enhanced drug delivery. Int. J. Biol. Macromol. 2019, 129, 477–487. [Google Scholar] [CrossRef]
- Lin, Y.-H. Multifunctional gentamicin supplementation of poly(γ-glutamic acid)-based hydrogels for wound dressing application. J. Appl. Polym. Sci. 2011, 120, 1057–1068. [Google Scholar] [CrossRef]
- Moritz, A.G. N–H Stretching Frequencies of Amines and Amides. Nature 1962, 195, 800. [Google Scholar] [CrossRef]
- Colthup, N.B.; Daly, L.H.; Wiberley, S.E. CHAPTER 11—AMINES, C=N, AND N=O COMPOUNDS. In Introduction to Infrared and Raman Spectroscopy, 3rd ed.; Colthup, N.B., Daly, L.H., Wiberley, S.E., Eds.; Academic Press: San Diego, CA, USA, 1990; pp. 339–354. [Google Scholar]
- Golovnev, N.N.; Molokeev, M.S.; Vereshchagin, S.N.; Atuchin, V.V. Calcium and strontium thiobarbiturates with discrete and polymeric structures. J. Coord. Chem. 2013, 66, 4119–4130. [Google Scholar] [CrossRef]
- Golovnev, N.N.; Molokeev, M.S.; Lesnikov, M.K.; Sterkhova, I.V.; Atuchin, V.V. Thiobarbiturate and barbiturate salts of pefloxacin drug: Growth, structure, thermal stability and IR-spectra. J. Mol. Struct. 2017, 1149, 367–372. [Google Scholar] [CrossRef]
- Golovnev, N.N.; Molokeev, M.S.; Lesnikov, M.K.; Atuchin, V.V. First outer-sphere 1,3-diethyl-2-thiobarbituric compounds [M(H2O)6](1,3-diethyl-2-thiobarbiturate)2·2H2O (M=Co2+, Ni2+): Crystal structure, spectroscopic and thermal properties. Chem. Phys. Lett. 2016, 653, 54–59. [Google Scholar] [CrossRef]
- Palanisamy, D.; Karuppannan, S. Nucleation Control and Growth of Metastable α-l-Glutamic Acid Single Crystals in the Presence of l-Phenylalanine. Procedia Eng. 2016, 141, 70–77. [Google Scholar] [CrossRef]
- Touyama, R.; Takeda, Y.; Inoue, K.; Kawamura, I.; Yatsuzuka, M.; Ikumoto, T.; Shingu, T.; Yokoi, T.; Inouye, H. Studies on the Blue Pigments Produced from Genipin and Methylamine. I. Structures of the Brownish-Red Pigments, Intermediates Leading to the Blue Pigments. Chem. Pharm. Bull. 1994, 42, 668–673. [Google Scholar] [CrossRef]
- Pujana, M.A.; Pérez-Álvarez, L.; Iturbe, L.C.C.; Katime, I. Biodegradable chitosan nanogels crosslinked with genipin. Carbohydr. Polym. 2013, 94, 836–842. [Google Scholar] [CrossRef] [PubMed]
- Dimida, S.; Barca, A.; Cancelli, N.; De Benedictis, V.; Raucci, M.G.; Demitri, C. Effects of genipin concentration on cross-linked chitosan scaffolds for bone tissue engineering: Structural characterization and evidence of biocompatibility features. Int. J. Polym. Sci. 2017, 2017, 8410750. [Google Scholar] [CrossRef]
- Moura, M.J.; Faneca, H.; Lima, M.P.; Gil, M.H.; Figueiredo, M.M. In situ forming chitosan hydrogels prepared via ionic/covalent co-cross-linking. Biomacromolecules 2011, 12, 3275–3284. [Google Scholar] [CrossRef]
- Chambon, F.; Winter, H.H. Linear viscoelasticity at the gel point of a crosslinking PDMS with imbalanced stoichiometry. J. Rheol. 1987, 31, 683–697. [Google Scholar] [CrossRef]
- Moura, M.J.; Figueiredo, M.M.; Gil, M.H. Rheological study of genipin cross-linked chitosan hydrogels. Biomacromolecules 2007, 8, 3823–3829. [Google Scholar] [CrossRef]

| Sample | O-CMCS (mg) | OHA (mg) | G/GluP (mg) |
|---|---|---|---|
| O-CMCS/OHA100 | 100.0 | 100.0 | - |
| O-CMCS/OHA75 | 100.0 | 75.0 | - |
| O-CMCS/OHA50 | 100.0 | 50.0 | - |
| O-CMCS/OHA25 | 100.0 | 25.0 | - |
| O-CMCS/OHA100-G/GluP | 100.0 | 100.0 | 2.0 |
| O-CMCS/OHA75-G/GluP | 100.0 | 75.0 | 2.0 |
| O-CMCS/OHA50-G/GluP | 100.0 | 50.0 | 2.0 |
Disclaimer/Publisher’s Note: The statements, opinions and data contained in all publications are solely those of the individual author(s) and contributor(s) and not of MDPI and/or the editor(s). MDPI and/or the editor(s) disclaim responsibility for any injury to people or property resulting from any ideas, methods, instructions or products referred to in the content. |
© 2024 by the authors. Licensee MDPI, Basel, Switzerland. This article is an open access article distributed under the terms and conditions of the Creative Commons Attribution (CC BY) license (https://creativecommons.org/licenses/by/4.0/).
Share and Cite
Beserra Junior, I.M.; de Sousa Lopes, D.; da Silva Barbosa, M.C.; da Silva Neto, J.E.; da Silva, H.N.; Fook, M.V.L.; Navarro, R.F.; Silva, S.M.d.L. Rheological Characterization of Genipin-Based Crosslinking Pigment and O-Carboxymethyl Chitosan–Oxidized Hyaluronic Acid In Situ Formulable Hydrogels. Polymers 2024, 16, 2615. https://doi.org/10.3390/polym16182615
Beserra Junior IM, de Sousa Lopes D, da Silva Barbosa MC, da Silva Neto JE, da Silva HN, Fook MVL, Navarro RF, Silva SMdL. Rheological Characterization of Genipin-Based Crosslinking Pigment and O-Carboxymethyl Chitosan–Oxidized Hyaluronic Acid In Situ Formulable Hydrogels. Polymers. 2024; 16(18):2615. https://doi.org/10.3390/polym16182615
Chicago/Turabian StyleBeserra Junior, Ivo Marquis, Débora de Sousa Lopes, Milena Costa da Silva Barbosa, João Emídio da Silva Neto, Henrique Nunes da Silva, Marcus Vinícius Lia Fook, Rômulo Feitosa Navarro, and Suédina Maria de Lima Silva. 2024. "Rheological Characterization of Genipin-Based Crosslinking Pigment and O-Carboxymethyl Chitosan–Oxidized Hyaluronic Acid In Situ Formulable Hydrogels" Polymers 16, no. 18: 2615. https://doi.org/10.3390/polym16182615
APA StyleBeserra Junior, I. M., de Sousa Lopes, D., da Silva Barbosa, M. C., da Silva Neto, J. E., da Silva, H. N., Fook, M. V. L., Navarro, R. F., & Silva, S. M. d. L. (2024). Rheological Characterization of Genipin-Based Crosslinking Pigment and O-Carboxymethyl Chitosan–Oxidized Hyaluronic Acid In Situ Formulable Hydrogels. Polymers, 16(18), 2615. https://doi.org/10.3390/polym16182615

